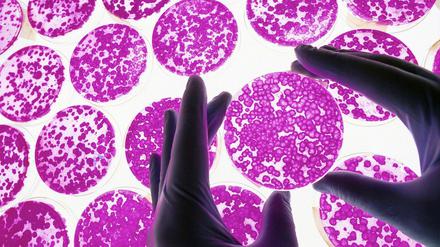
Nur scheinbar gleich. In der Petrischale sehen zu Stammzellen umprogrammierte Zellen alle gleich aus.

BP scheint zum ersten Mal echte Erfolge im Kampf gegen die Ölpest zu verbuchen. Doch schon tauchen neue Vorwürfe gegen den Konzern auf. Welche Rolle hat der Energieriese bei der Freilassung des Attentäters von Lockerbie gespielt?
Alle Tagesspiegel-Artikel vom 19.07.2010

Drei Spanier haben sich unter den Top Ten platziert. Alberto Contador übernahm am Montag sogar das Gelbe Trikot des Führenden. Diese Dominanz weckt Verdacht.

Die Zahl der gefälschten Banknoten steigt: Immer wieder tauchen auch kuriose Blüten auf. Den Schaden haben die Einzelhändler.

Der Unmut von Passagieren der größten britischen Fluggesellschaft Easyjet nimmt zu – sie wollen Ausgleichzahlungen geltend machen und prüfen Klagen. Auch das Luftfahrtbundesamt will sich einschalten.
Die Rücktrittsankündigung des Hamburger Bürgermeisters Ole von Beust und die Ablehnung der Schulreform haben in der CDU die Debatte über den Verlust an politischem Profil unter der Parteichefin Angela Merkel neu entfacht.
Diskus-Weltmeister Robert Harting und Hochsprung- Hoffnung Ariane Friedrich führen das deutsche Leichtathletik-Team zu den 20. Europameisterschaften nach Barcelona.

Dawidenko hofft auf eine Titelverteidigung beim Hamburger Tennisturnier

Uli Hoeneß kandidiert doch nicht als Liga-Chef

Patrick Ebert ist das Kreuzband gerissen. Er wird Hertha BSC ein halbes Jahr fehlen, seine Position könnte Daniel Beichler einnehmen.
Ein Zivilbeamter wurde niedergestochen, der andere getreten und geschlagen. Die Täter sind 18- und 19-Jährige. Am Montag begannen die Prozesse, eine Anklage lautet auf versuchten Mord.
Er erweckte die Arena an der Spree und den Admiralspalast zu neuem Leben Nun wurde Falk Walter vorläufig ein Insolvenzverwalter vor die Nase gesetzt
Die Bühne ist gemietet, viele Gäste haben zugesagt, es wird schließlich ein kleines Jubiläum gefeiert. Im Herbst steht die zehnte Berliner Benefizgala „Künstler gegen Aids“ an, die auch in diesem Jahr von Schauspieler Dirk Bach moderiert wird.
Berlin - Volkswagen-Vorzugsaktien sind am Montag ans Dax-Ende gefallen. Anleger trennten sich von dem Papier, weil auf den Wolfsburger Autohersteller möglicherweise milliardenschwere Schadenersatzklagen zukommen.
Die heißen Sommertage bescheren den Eisherstellern eine riesige Nachfrage und sorgen dafür, dass die Mitarbeiter inzwischen Sonderschichten fahren müssen.
Der Dax hat seine Anfangsgewinne am Montag nicht halten können. Er drehte am Nachmittag ins Minus und notierte bei Handelsschluss 0,5 Prozent schwächer bei 6009 Punkten.

Der Aufschwung ist da. Die Bundesbank traut der deutschen Wirtschaft ein „außerordentlich kräftiges“ Wachstum zu.

Mit der für diese Legislaturperiode geplanten Angleichung der Rentenberechnung in Ost- und Westdeutschland lässt sich die Bundesregierung Zeit.
Reprogrammierte Zellen „erinnern“ sich an ihr früheres Leben. Das könnte ihren Einsatz in der Medizin erschweren.
Mehr als 60 Menschen sterben bei einem Zugunglück in Indien – Vorwürfe gegen die Bahngesellschaft

Umbruch in Hamburg: Der Rückzug des ersten Bürgermeisters hat die Koalition in Hamburg und die gesamte CDU erschüttert. Wie geht es nach dem Volksentscheid weiter?
Der Zoo Berlin hat die Einrichtung eines beratenden Beirats für Zoo und Tierpark als überflüssig bezeichnet und abgelehnt. Es seien bereits genügend Experten und Politiker in den Aufsichtsräten von Zoo AG und Tierpark GmbH vertreten, sagte Zoo-Vorstand Bernhard Blaszkiewitz.
GRUNDSCHULEIn Berlin gibt es seit der Nachkriegszeit die sechsjährige Grundschule, sie hat in der Bevölkerung kaum noch Diskussionpotential. In Ausnahmen können Kinder schon nach vier Jahren auf sogenannte grundständige Gymnasien wechseln.
Der angeschlagene britische Ölkonzern BP hat mit seinem zweitgrößten deutschen Wettbewerber RWE ein besonders großes Gasförderprojekt auf den Weg gebracht.
Der Krankenstand von Arbeitnehmern ist im ersten Halbjahr 2010 auf den höchsten Stand seit fünf Jahren gestiegen.
Der Aufschwung ist zurück, die Arbeitslosigkeit geht zurück – schon lassen die Beschäftigten ihren Chef einen guten Mann sein und melden sich krank.
Jeder einzelne Abgang, sechs an der Zahl sind es inzwischen, hat seine eigene Geschichte. Und die hat mit dem jeweiligen Ministerpräsidenten aus den Reihen der CDU zu tun. Aber in der Summe hat es dann doch etwas für die CDU-Vorsitzende zu bedeuten.
In Friedrichshain sind Polizisten bei einem Einsatz in der Liebigstraße möglicherweise mit einer ätzenden Flüssigkeiten überschüttet worden. Die Beamten klagten über Haut- und Schleimhautreizungen.
Erst hieß es beim Fernsehsender Das Vierte "Wir sind Hollywood", dann wurde der Kanal Abspielstation für Abgehangenes. Nun wagt Ex-N-24-Chef Ulrich Ende einen Neustart mit dem Spartensender. Mit Erfolg?
Das neue schwarz-grüne Traumduo hat Charme und Zukunft. Aber eine Mehrheit der Bürger der Hansestadt hat das herausragende Reformprojekt der bürgerlichen Regierung in die Tonne getreten.
Nach Frostschäden im Winter gibt es jetzt Hitzeschäden an den Straßen. Weil sich die Betonfahrbahn gewölbt hat und aufgebrochen ist, waren am Montag auf der Autobahn A 113 am Teltowkanal an der Anschlussstelle Späthstraße stadteinwärts nur noch zwei Fahrspuren befahrbar.

Deutschland hat die UN-Konvention zum Verbot von Streu- und Splitterbomben unterzeichnet. Bis März 2010 hat aber eine Schifffahrtsgesellschaft Streumunition transportiert - unter der Flagge von Antigua und Barbuda.
Es ist kaum ein Jahr her, da wurde der Senat aufgefordert sich für eine Herabsetzung des Strafmündigkeitsalters auf zwölf Jahre einzusetzen. Doch den Jungen in diesen Milieus fehlt weniger Strafe denn Zuwendung und Fürsorge.
Die ehemalige Markthalle des Blumengroßmarkts an der südlichen Friedrichstraße wird an die Stiftung Jüdisches Museum Berlin verkauft. Der Aufsichtsrat der Berliner Großmarkt GmbH habe der Veräußerung des 10 000 Quadratmeter großen Grundstückes zugestimmt, teilte der Liegenschaftsfonds mit, der mit dem Verkauf des Areals beauftragt ist.
Weil er die Terrororganisation Al Qaida mit Geld und Kampfgerät unterstützt hat, ist ein Mann am Montag vom Oberlandesgericht Koblenz zu sechs Jahren Haft verurteilt worden. Der Türke hatte Geld und Geräte besorgt.
Gegründet wurde er erst 400 Jahre nach der Reformation, und zwar 1947 in der schwedischen Stadt Lund, als Nachfolgeorganisation des Lutherischen Weltkonvents. Mittlerweile gehören dem Dachverband 140 Mitgliedskirchen in 78 Ländern an.
Die Landesverkehrswacht dringt auf eine Bundesratsinitiative Brandenburgs für eine Null-Promille-Grenze.
Einen Unfall mit einem Schaden in Höhe von mehr als 200.000 Euro hat am Montag ein Lastwagenfahrer auf dem östlichen Berliner Ring verursacht.
Im Bendlerblock findet die erste gesamtdeutsche Gedenkstunde statt
Eine junge Polizistin soll ihr Baby getötet und mit einem Stein beschwert an einem Fluss in Niedersachsen vergraben haben.
Natürlich ist die schulfreie Zeit für viele Kinder eine notwendige Pause vom Lernen im Klassenzimmer – eine wohlverdiente Phase ohne Schulbücher und Prüfungen. Das muss aber nicht heißen, dass Schüler die gesamten sechs Wochen nichts lernen wollen.

Gemeinsam gegen Google: Die Fraktionen von SPD und Linken in Berlin wollen den Datenschutz im Internet ausbauen. Rot-Rot lehnt die Aufnahmen für den Geodaten-Dienst Street View ab.
Parken bleibt billig, geblitzt wird wenig. Berlin kassiert lieber in Bus und Bahn. Gastkommentator Michael Cramer findet das nicht richtig. Und was denken Sie? Sollten die öffentlichen Verkehrsmittel günstiger werden? Und muss Autofahren teurer werden? Diskutieren Sie mit!
Etwas ganz Besonderes zum Chopin-Jahr haben sich die drei Musiker Naoko Fukomoto (Klavier), Minjung Kang (Violine, Foto) sowie Uwe Hirth-Schmidt (Violoncello) einfallen lassen: Sie spielen das gesamte kammermusikalische Werk des Jubilars Fryderyk Franciszek Chopin, der vor knapp 200 Jahren geboren wurde. Mit im Programm ist auch die „Polonaise brillante für Violoncello und Klavier“, die der polnische Ausnahmekomponist mit 18 Jahren für den Prinzen Radziwill schrieb.
Wenn ein Autor unterhaltsam schreibt, dann schreien die Zweifler auf: Kann das denn wirklich „Literatur“ sein, wenn man es versteht, ohne den Satzbau dreimal aufzudröseln und mehrere Nachschlagewerke zu konsultieren? Ja, es kann.
Muttersein bedeute Hingabe, hatte man mir vor der Geburt gesagt. Als weitere Synonyme fürs Muttersein wurden ferner genannt: keine Zeit mehr für sich, ewige Müdigkeit.

Rund 20 Menschen gedachten der 41 jüdischen Männer, die vor 500 Jahren auf dem heutigen Strausberger Platz öffentlich verbrannt wurden, für eine Tat, die sie nicht begangen hatten.
Sieben Millionen Euro fließen jährlich an Zuschüssen an den Zoo und den Tierpark. Nun will die Politik durchsetzen, dass das Geld sinnvoller ausgegeben wird.
Das jüdische Museum kauf die ehemalige Markthalle des Blumengroßmarktes an der südlichen Friedrichstraße. Dort soll eine Akademie entstehen - sowie neuer Raum für Kultur- und Bildungsveranstaltungen.